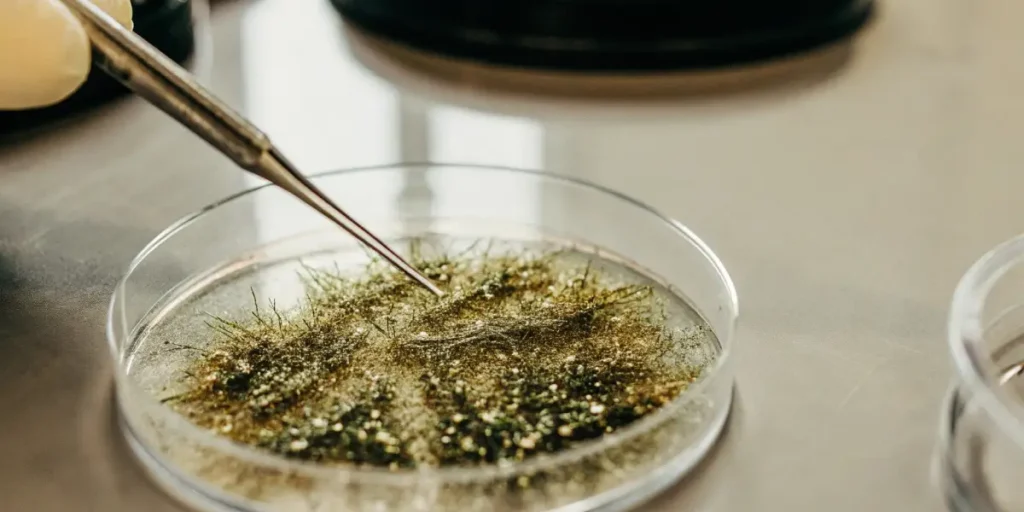
Petri dish with cannabis trichomes being analyzed under a microscope.

Enzymatic vs Synthetic Cannabinoid Conversion
The world of cannabis is vast and varied, and one of the more intriguing aspects is how cannabinoids can be converted. Enzymatic vs synthetic cannabinoid conversion is a topic worth delving into for both novice and experienced cannabis enthusiasts. This process can impact the final product significantly, affecting everything from potency to therapeutic effects.
When talking about enzymatic conversion of cannabinoids to synthetic types, the focus is primarily on using biological catalysts. Enzymes are proteins that speed up chemical reactions, making the conversion process more natural. This is a method cherished by many who prefer organic processes in their cultivation and consumption.
Recommended Strains
Pineapple Kush Regular
| | THC | 16% - 19% (Medium) |
| | Type | Regular |
| | Yield | Medium |
| | Phenotype | 60% Indica / 40% Sativa |
Pink Gorilla
| | THC | 18% - 22% (Medium) |
| | Type | Feminized |
| | Yield | High |
| | Phenotype | 75% Indica / 25% Sativa |
On the flip side, synthetic cannabinoid creation using chemical processes offers precision and consistency. This method is often preferred by industries that require large-scale production due to its efficiency. Both methods have their place in the cannabis world, each with unique advantages and challenges.
Differences Between Enzymatic and Synthetic Cannabinoid Production
One key difference lies in the source of the conversion process. Enzymatic methods rely on natural catalysts found in living organisms. These are often considered more environmentally friendly, as they mimic processes occurring in nature. For example, when cultivating strains like Blue Dream from Blimburn Seeds, using enzymatic processes can enhance the natural terpene profile.
Synthetic processes, however, are lab-based and involve chemical reactions. This can lead to a higher yield and more consistent results, which is crucial for large-scale operations. For those growing strains such as Gelato from Blimburn Seeds, synthetic methods can ensure a steady supply of cannabinoids with each harvest.
Knowing the differences between enzymatic and synthetic cannabinoid production is crucial for growers aiming to optimize their crops. Enzymatic methods often emphasize quality and authenticity, catering to a niche market that values traditionally cultivated products. Meanwhile, synthetic production is geared towards efficiency and reliability, appealing to markets that prioritize quantity and consistency.
Another distinction lies in the regulatory landscape surrounding these methods. Enzymatic conversion of cannabinoids to synthetic forms may face fewer regulatory hurdles due to its natural approach. However, synthetic processes might require more rigorous testing and compliance checks to ensure safety and effectiveness, particularly in the pharmaceutical industry.
Efficiency of Enzymatic vs Synthetic Cannabinoid Processes
Efficiency is a major consideration in this debate. Enzymatic processes can be slower as they rely on the conditions ideal for enzymes to function. This involves maintaining specific temperatures and pH levels, which can be tricky but rewarding in terms of product quality.
In contrast, synthetic processes are generally faster. They can be controlled more tightly, allowing for rapid production. This is beneficial for growers who need to meet high demand or those investing in strains like Pineapple Express from Blimburn Seeds, where high turnover is crucial.
Despite the slower pace, enzymatic methods for converting cannabinoids to synthetic forms can enhance certain desirable traits in the final product. The quality of flavors and aroma, as well as the preservation of a wider range of cannabinoids, can make this process worthwhile for those targeting a premium market segment.
Efficiency of enzymatic vs synthetic cannabinoid processes also extends to resource utilization. Enzymatic methods may require more time and precision but often use fewer chemicals, aligning with eco-friendly practices. Conversely, synthetic processes may consume more resources but offer a streamlined production line, maximizing output with minimal variability.
Promos & Deals
Practical Applications in Cannabis Cultivation
In practical terms, choosing between enzymatic and synthetic methods depends on your priorities. Enzymatic methods are often favored by organic farmers and those who emphasize sustainability. These methods can be more labor-intensive but offer a product that many argue is more ‘natural’.
For synthetic processes, the focus is on scale and consistency. Large operations benefit from the predictability and control offered by synthetic methods, making it easier to produce uniform batches. This is particularly useful when producing medical-grade products where precise cannabinoid content is essential.
Enzymatic vs synthetic cannabinoid conversion plays a critical role in defining the cultivation strategy. Small-scale growers might lean towards enzymatic methods to create boutique products that resonate with artisanal values. This approach can lead to niche marketing opportunities, attracting consumers who value craftsmanship over mass production.
Meanwhile, commercial cultivators may find synthetic cannabinoid creation using enzymatic processes a promising hybrid approach. By integrating both methods, growers can enhance product quality while maintaining the efficiency needed for larger markets, striking a balance between innovation and tradition.

Real-Life Examples and Strain Selection
Consider a grower cultivating Blue Dream for its relaxing effects. Using enzymatic conversion can enhance its soothing properties, making it ideal for stress relief. This aligns with the growing demand for natural wellness products.
On the other hand, a commercial grower focused on strains like Gelato might opt for synthetic methods. The goal here is to maintain a reliable supply chain for dispensaries, ensuring that each batch meets exacting standards.
In real-world scenarios, enzymatic vs synthetic cannabinoid conversion significantly impacts strain selection. A grower dedicated to producing high-quality craft cannabis might choose strains that benefit from enzymatic conversion, such as those with complex terpene profiles that appeal to connoisseurs.
Conversely, operations focused on high-volume production may favor strains suited for synthetic cannabinoid creation using enzymatic processes. This strategy ensures that the efficiency of synthetic methods is complemented by the nuanced qualities enzymes provide, broadening the appeal of their product range.
FAQs
What is enzymatic conversion of cannabinoids to synthetic?
Enzymatic conversion involves using natural enzymes to transform cannabinoids from one form to another. This process takes advantage of biological catalysts that occur naturally. It’s a method many growers find appealing due to its alignment with organic farming principles.
In contrast, synthetic conversion uses chemical methods to achieve the same end. While both aim to modify cannabinoids, the approaches differ fundamentally in their execution and end results. This choice often depends on the grower’s priorities, such as sustainability versus efficiency.
Knowing enzymatic conversion of cannabinoids to synthetic is essential for making informed cultivation decisions. This approach can lead to a product that is not only effective but also aligns with consumer expectations regarding natural and sustainable farming practices.
Additionally, growers exploring synthetic conversion might consider combining it with enzymatic methods to achieve a balance between natural processes and industrial efficiency. This hybrid strategy can optimize production while maintaining the integrity of the final product.
How do enzymatic methods differ from synthetic cannabinoid production?
The main difference is in how the conversion is achieved. Enzymatic methods use biological processes, while synthetic methods rely on chemical reactions in a lab. This distinction can affect the quality and characteristics of the final product.
For example, enzymatic methods might preserve more of the plant’s natural properties, leading to a richer flavor and aroma. Synthetic processes, however, can produce cannabinoids more quickly and consistently, which is beneficial for large-scale operations.
Exploring the differences between enzymatic and synthetic cannabinoid production can reveal insights into the overall impact on the cannabis industry. While enzymatic methods focus on enhancing the plant’s natural attributes, synthetic methods excel in meeting the demands of scalability and uniformity.
Growers often choose their approach based on market needs and consumer preferences. Those prioritizing authenticity and environmental stewardship may find enzymatic methods more appealing, whereas those targeting efficiency and consistency may prefer synthetic production.
Why choose enzymatic conversion over synthetic methods?
Enzymatic conversion is often chosen by those who prioritize natural processes. It can yield a product that is considered closer to what nature intended. This method appeals to consumers who are cautious about synthetic additives and prefer organic products.
However, it’s important to recognize that enzymatic processes can be more complex and time-consuming. Despite this, the end result often justifies the effort for those who seek a more ‘authentic’ cannabis experience.
The choice of enzymatic vs synthetic cannabinoid conversion can be driven by a commitment to sustainability and quality. Enzymatic methods offer the potential for a more refined product, aligning with the values of consumers who prioritize environmental impact and natural production methods.
Moreover, enthusiasts who appreciate the subtleties of flavor and aroma in cannabis may find enzymatic conversion particularly rewarding. This approach allows for a depth of character in the final product that synthetic methods might not fully capture, catering to the discerning tastes of a specialized market.
What are the efficiency benefits of synthetic cannabinoid processes?
Synthetic processes are typically more efficient in terms of time and yield. They allow for precise control over the conversion process, which can lead to higher consistency in cannabinoid content. This is crucial for medical cannabis where exact dosages are required.
For commercial growers, the ability to produce large quantities quickly can be a significant advantage. This efficiency supports the demands of a growing market, providing a stable supply to meet consumer needs.
Efficiency of enzymatic vs synthetic cannabinoid processes is a pivotal factor for growers aiming to scale operations. Synthetic methods provide a level of precision and predictability that meets the rigorous standards of pharmaceutical-grade production, ensuring safety and efficacy.
Additionally, for businesses navigating competitive markets, the rapid turnaround and high throughput of synthetic processes can be a decisive advantage. This approach allows producers to respond swiftly to market trends and consumer demands, maintaining a competitive edge.
Can synthetic cannabinoid creation use enzymatic processes?
Yes, it is possible to combine both methods. Some modern techniques involve using enzymes within a synthetic framework to create cannabinoids. This hybrid approach can offer the best of both worlds, maintaining natural qualities while ensuring efficiency.
This method is particularly appealing for innovative growers looking to enhance their product offerings. By integrating enzymes into synthetic processes, they can potentially create unique cannabinoid profiles that stand out in the market.
Employing enzymatic methods for converting cannabinoids to synthetic forms within a synthetic framework presents a novel approach to cultivation. This technique leverages the strengths of both methods, optimizing production while preserving beneficial plant characteristics.
Innovative growers exploring this hybrid strategy can differentiate their products in a crowded marketplace. By crafting unique cannabinoid profiles with enhanced therapeutic and sensory attributes, they cater to a diverse consumer base seeking both efficacy and excellence.















